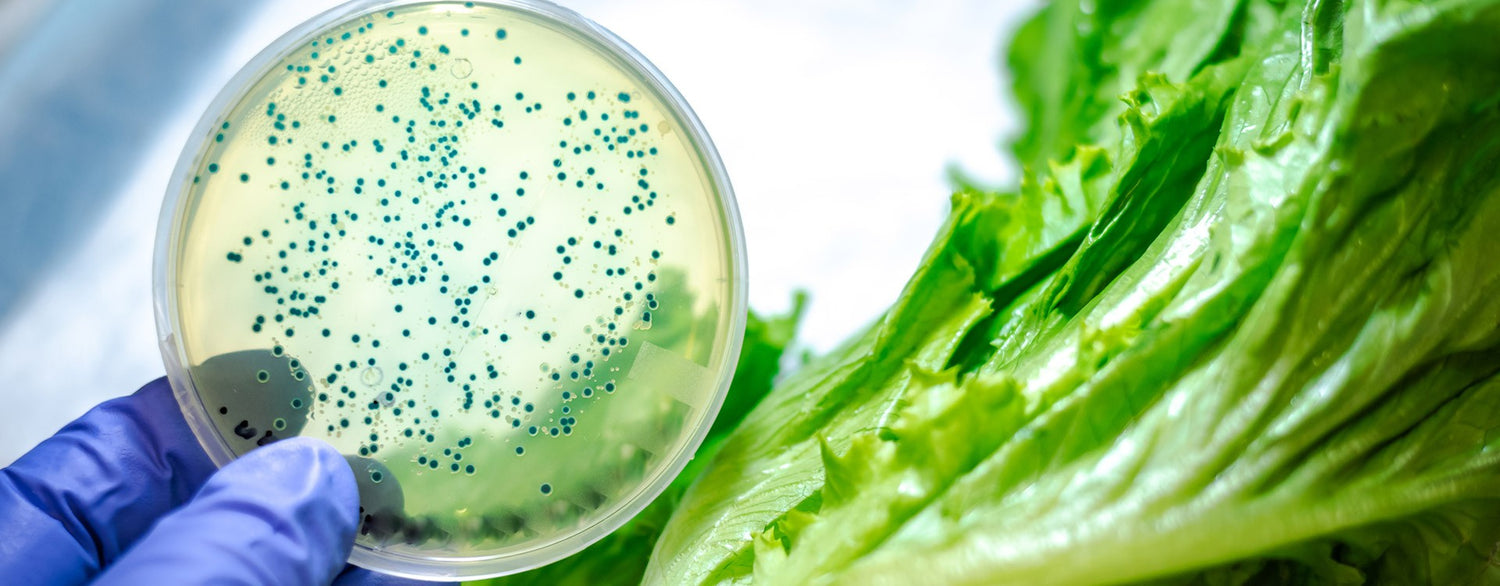
The impact of oregano (origanum heracleoticum) essential oil and carvacrol on virulence gene transcription by escherichia coli O157:H7

Enterohaemorrhagic Escherichia coli (EHEC) serotype O157:H7was first recognized as a food pathogen in 1982 (Paton and Paton 1998). Since then, this organism has been implicated in sporadic cases and outbreaks of enterohaemorrhagic diarrhea worldwide (EFSA and ECDC 2013; Crim et al., 2014). EHEC O157:H7 is a member of the attaching and effacing (A/E) E. coli group. It possesses virulence factors essential for adhesion of the pathogen to intestinal epithelial cells (attachment) and is responsible for the destruction of the brush border ofmicrovilli (effacement) (Paton and Paton 1998).
Poursuivre la lecture
Sport et huiles essentielles : préparer muscles et articulations
La rentrée est passée et beaucoup d'entre nous ont repris une activité physique avec beaucoup de plaisir. Le sport est excellent pour la santé mais il ne se fait pas toujours sans mal ! L'échauffement est primordial dans la plupart des cas, et surtout si l'on se prépare à d'intenses efforts ou si l'on avait cessé l'activité physique depuis longtemps... Certaines Huiles Essentielles peuvent nous aider à préparer les muscles et les articulations à l'effort. C'est ce que le spray AROMALGIC nous propose. Aromalgic Spray, formule concentrée ! Pranarôm vous propose un spray très efficace et très pratique à base d'Huiles Essentielles. La gamme Aromalgic existe également sous forme d'huile de massage, idéale après l'exercice ou en traitements de fond pour les articulations douloureuses. Le spray AROMALGIC fait appel aux meilleures Huiles Essentielles pour la sphère articulaire, tendineuse et musculaire. On retrouve dans la formule du spray AROMALGIC les Huiles Essentielles suivantes : l'incontournable Gaulthérie couchée (gaultheria procumbens) : une Huile Essentielle réputée pour son action anti-inflammatoire et antalgique ; la Menthe des champs (mentha arvensis) : une menthe fraîche à l'effet glaçon pour une action antalgique ; l'Eucalyptus citronné (eucalyptus citriodora) : l'Huile Essentielle "pompier" qui apaise le feu de l'inflammation ; la Litsée citronnée (litsea citrata) : pour la détente, la souplesse et l'échauffement préalable à l'effort ; le Lavandin (lavandula burnatii ou grosso) : On l'oublie parfois mais le lavandin est également réputé être un bon antalgique ; le Pin sylvestre (pinus sylvestris) : Une Huile Essentielle des plus toniques pour préparer l'organisme à l'effort ; le Cannelier de Chine (cinnamomum cassia) : Bien dosée, la cannelle est une essence des plus toniques et des plus échauffantes ; le Katrafay (Cedrelopsis grevei) : la star qui vient de Madagascar et nous prodigue ses bienfaits. Une Huile Essentielle idéale pour calmer l'inflammation et assouplir les tissus. Le spray AROMALGIC s'utilise dans tous les sens (même à l'envers pour atteindre l'arrière des membres). En cas d’inconfort musculaire et/ou articulaire, vaporisez 2 à 3 fois par jour sur la zone corporelle concernée. Pour l’échauffement avant l’activité physique: vaporisez localement.
Les Huiles Essentielles contre les Troubles de la Digestion
Les Huiles Essentielles contre la digestion difficile Les huiles essentielles représentent une solution naturelle efficace pour apaiser les troubles digestifs. Que vous souffriez de ballonnements, gaz, maux de ventre, nausées, reflux gastriques ou d’une digestion lente, elles peuvent vous aider à retrouver un confort digestif. Dans cet article, nous explorerons les meilleures huiles essentielles pour améliorer la digestion, leurs utilisations, ainsi que les synergies possibles pour chaque trouble digestif. 1. Les 12 huiles essentielles qui facilitent la digestion Voici 12 huiles essentielles qui peuvent vous aider avec la majorité des troubles digestifs, soulager les douleurs et les inconforts et améliorer la digestion. 1. Huile essentielle de Menthe poivrée L’huile essentielle de menthe poivrée est l’une des HE les plus efficaces pour soulager les problèmes de digestion. Elle possède des propriétés antispasmodiques, anti-nauséeuses et analgésiques, qui aident à soulager maux de ventre, crampes d’estomac, ballonnements, nausées, vomissements, indigestions, mal de transport et gueules de bois ! Utilisation : Voie interne : 1 ou 2 gouttes dans une cuillère de miel ou un sucre de canne à sucer. Voie externe : 1 à 2 gouttes dans une Huile Végétale (HV) à appliquer sur le ventre, ou le front pour la gueule de bois, en massant doucement. Respirer directement au flacon (nausées). Contre-indications : Elle est déconseillée chez la femme enceinte et allaitante et aux enfants de moins de 6 ans. 2. Huile essentielle de Mandarine L’huile essentielle de mandarine possède des propriétés toniques digestives, carminatives et laxatives douces, ce qui en fait un excellent choix pour traiter les dyspepsies, l’aérophagie et la constipation. Utilisation : Voie interne : prenez 2 gouttes d’essence de mandarine, 3 fois par jour, dans un peu de miel, de l’huile d’olive ou sur un sucre de canne, sous la langue, pour aider à la digestion. Voie externe : mélangez 3 à 4 gouttes avec 3 à 4 gouttes d’HV et frictionnez sur la face interne des poignets ou le plexus solaire, 3 fois par jour, pour un effet calmant. Contre-indications : L’huile essentielle de mandarine est déconseillée pendant les 3 premiers mois de grossesse. Elle ne doit pas être appliquée avant une exposition au soleil et peut provoquer une irritation cutanée si utilisée pure. 3. Huile essentielle de Coriandre L’huile essentielle de coriandre est réputée pour ses bienfaits sur les troubles digestifs. Elle possède des propriétés antibactériennes, antivirales et antiparasitaires, ce qui la rend très utile pour traiter les ballonnements, les gaz, l’indigestion et la gastrite. Utilisation : Voie interne : prenez 2 gouttes 3 à 4 fois par jour, dans du miel, de l’huile d’olive ou sur un morceau de sucre de canne, sous la langue. Voie externe : mélangez 4 gouttes d’HE avec 4 gouttes d’huile végétale de noisette et massez le mélange sur le ventre. Contre-indications : Elle est déconseillée pendant les trois premiers mois de grossesse et chez les enfants de moins de 6 ans. 4. Huile essentielle de Basilic Exotique L’huile essentielle de Basilic exotique à des propriétés tonifiantes, stimulantes, anti-inflammatoires et anti-infectieuses. Elle soulage les ballonnements, les colites et les gastro-entérites. Elle contribue à apaiser les symptômes d’une digestion difficile et à calmer l’inflammation intestinale. Utilisation : Voie interne : 1 à 2 gouttes sur du miel ou de l’huile végétale 3 fois par jour. Voie externe : mélangez 3 à 4 gouttes d’HE avec 3 à 4 gouttes d’une HV, puis massez le ventre. Contre-indications : Elle est déconseillée pendant les 3 premiers mois de grossesse, durant l’allaitement, et chez les enfants de moins de 3 ans. 5. Huile essentielle de Citron (zeste) Les propriétés tonifiantes, carminatives et dépuratives de l’huile essentielle de Citron, extraite du zeste du fruit, stimulent le système digestif, facilitent l’élimination des gaz, et soulagent acidité gastrique, brûlures d’estomac, ballonnements et douleurs abdominales. Utilisation : Voie interne : 2 gouttes, 3 fois par jour, dans du miel, de l’huile d’olive ou sur un sucre de canne, sous la langue. Voie externe : mélangez 2 gouttes avec 2 gouttes d’HV de noisette. Appliquez ce mélange localement sur la peau, 2 fois par jour. Contre-indications : Elle peut provoquer des irritations cutanées si elle est utilisée pure. Évitez de l’appliquer avant une exposition au soleil, car elle est photo sensibilisante. 6. Huile essentielle de Cannelle de chine L’huile essentielle de Cannelle de Chine est un puissant remède digestif. Elle possède des propriétés antibactériennes, antifongiques et antiparasitaires, ce qui la rend efficace contre les infections gastro-intestinales, les diarrhées et les dysenteries. Utilisation : Voie interne : mélangez 1 goutte avec 10 gouttes d’huile végétale de noisette, et prenez ce mélange jusqu’à 4 fois par jour pour traiter les affections bactériennes et parasitaires. Voie externe : diluez 1 goutte dans une HV et appliquez-la sur le ventre, mais utilisez-la avec précaution, car elle peut être irritante. Contre-indications : Cette huile essentielle est déconseillée chez les enfants, les femmes enceintes et allaitantes. Elle peut causer des irritations cutanées lorsqu’elle est utilisée pure, il est donc important de la diluer. 7. Huile essentielle de Gingembre L’huile essentielle de Gingembre possède des propriétés toniques, digestives, carminatives et stomachiques, ce qui en fait un excellent remède pour les dyspepsies, flatulences, indigestions, aérocolies, inappétences et constipation. Elle est aussi reconnue pour son efficacité contre les nausées et vomissements. Utilisation : Voie interne : 1 à 2 gouttes dans du miel, 3 fois par jour, pour les gaz intestinaux, les nausées et les dyspepsies. Voie externe : mélangez 3 à 4 gouttes avec 4 gouttes d’HV et appliquez le mélange sur l’abdomen pour soulager la constipation. Contre-indications : Elle est déconseillée pendant les 3 premiers mois de grossesse. Elle peut provoquer des irritations cutanées lorsqu’elle est utilisée pure. 8. Huile essentielle d’Estragon L’huile essentielle d’Estragon détient des propriétés antispasmodiques et carminatives qui lui permettent de soulager les ballonnements, spasmes gastro-intestinaux et gaz intestinaux. Cette huile essentielle est également appréciée pour sa capacité à calmer les fermentations intestinales. Utilisation : Voie interne : 1 à 2 gouttes sur un support neutre, miel, huile végétale ou sucre de canne, 2 à 3 fois par jour. Voie externe : mélangez 2 à 3 gouttes avec une HV, puis appliquez le mélange sur le ventre en massant doucement, 2 à 3 fois par jour si nécessaire. Contre-indications : Elle est déconseillée pendant les 3 premiers mois de grossesse et chez les enfants de moins de 6 ans. 9. Huile essentielle de Carvi L’huile essentielle de Carvi possède des propriétés stimulantes, carminatives et cholagogues, ce qui signifie qu’elle stimule la digestion et aide à expulser les gaz. Elle est particulièrement efficace pour soulager les flatulences, éructations, ballonnements, crampes intestinales et de l’estomac. Utilisation : Voie interne : prenez 2 gouttes sur un support neutre, miel ou huile végétale, 3 fois par jour. Voie externe : mélangez 3 à 4 gouttes avec une HV. Appliquez le mélange sur le ventre, 3 à 4 fois par jour si nécessaire. Contre-indications : L’huile essentielle de carvi est contre-indiquée pendant la grossesse et chez les enfants de moins de 6 ans. 10. Huile essentielle de Cardamome L’huile essentielle de Cardamome est carminative et possède des propriétés antispasmodiques, anti-inflammatoires et apaisantes, ce qui la rend efficace contre les ballonnements, l’aérophagie, les fermentations et les spasmes gastro-intestinaux. Elle favorise la digestion en réduisant la formation de gaz dans le système digestif et en facilitant leur évacuation. Utilisation : Voie interne : mélangez 2 gouttes dans du miel, de l’huile végétale, ou sur un support neutre. Prenez ce mélange 3 fois par jour ; Voie externe : mélangez 4 gouttes avec 4 gouttes d’HV. Appliquez le mélange sur le ventre en massant en mouvements circulaires, dans le sens des aiguilles d’une montre, 3 à 4 fois par jour. Contre-indications : Elle est déconseillée aux enfants de moins de 3 ans et pendant les 3 premiers mois de grossesse. 11. Huile essentielle de Fenouil L’huile essentielle de Fenouil est reconnue pour ses propriétés antispasmodiques, stomachiques et carminatives, ce qui la rend particulièrement bénéfique pour les troubles digestifs et hépatiques variés. Utilisation : Voie interne : prenez 2 gouttes dans un peu de miel ou d’huile végétale de noyau d’abricot, trois fois par jour pour les troubles digestifs. Voie externe : mélangez 4 gouttes avec 4 gouttes d’huile végétale de noyau d’abricot, et appliquez ce mélange 3 fois par jour. Contre-indications : Elle est déconseillée pendant les 3 premiers mois de grossesse. 12. Huile essentielle de Cumin Le cumin est une huile incontournable pour tout problème digestif. Ses propriétés eupeptiques, carminatives et calmantes en font une excellente solution pour les dyspepsies, les colites, les flatulences, les constipations et l’aérophagie. Utilisation : Voie interne : prenez 2 gouttes sur un support neutre, dans du miel, de l’huile végétale ou directement sous la langue, 2 à 3 fois par jour. Voie externe : mélangez 3 gouttes avec 7 gouttes d’une HV. Massez le mélange sur l’abdomen, dans le sens des aiguilles d’une montre, jusqu’à 3 fois par jour. Contre-indications : L’huile essentielle de Cumin peut causer une irritation cutanée (dermocaustique) à l’état pur. Elle doit être diluée pour une utilisation externe et est déconseillée chez les enfants de moins de 3 ans et chez les femmes enceintes. Oléocaps+ 3 BIO de Pranarôm à base d’huiles essentielles de Menthe poivrée, de Cardamome, de Gingembre, de Cannelle de Chine, de Carvi et de Citron a été spécialement conçu pour vous soutenir en cas de troubles de la digestion, pour prévenir les suites de repas copieux et le mal des transports. 2. Les synergies d’huiles essentielles contre les troubles de la digestion Voici nos recettes pour traiter les problèmes digestifs spécifiques. Elles utilisent les synergies des HE pour créer un effet plus efficace. Pour l’huile végétale, nous avons choisi l’huile de macadamia qui convient à toutes les préparations. HE pour soulager mal au ventre, colique ou crampes Synergie apaisante à masser, en cas d’inconforts, de douleurs ou de crampes au niveau du ventre : 40 gouttes de Gingembre 40 gouttes de Fenouil 20 gouttes de Camomille noble 50 gouttes d’huile végétale de Macadamia Appliquez 3 à 4 gouttes, massez le sens des aiguilles d’une montre 3 à 4 fois par jour. HE contre les ballonnements Mélange d’HE pour venir à bout des ballonnements : 30 gouttes de Basilic exotique - ct linalol 10 gouttes de Cardamome 10 gouttes de Gingembre 50 gouttes d’huile végétale de Macadamia Appliquez 6 à 8 gouttes, massez le ventre et/ou 2 à 4 gouttes en bouche. 3 fois par jour. HE contre l’aérophagie Notre mélange préféré contre l’aérophagie : 40 gouttes de Gingembre 40 gouttes de Coriandre 20 gouttes de Citron (zeste) 50 gouttes d’huile végétale de Macadamia 3 gouttes dans une cuillère à café de miel, d’huile d’olive ou un morceau de sucre à sucer après les repas. HE contre la constipation Synergie à masser pour aider le transit en cas de paresse intestinale : 30 gouttes de Gingembre 20 gouttes de Mandarine 50 gouttes d’huile végétale de Macadamia Appliquez 6 à 8 gouttes sur le ventre et massez 3 ou 4 fois par jour et/ou 4 gouttes en bouche 2 fois par jour. HE contre la diarrhée Pour aider à soulager une diarrhée : 25 gouttes de Tea-tree 15 gouttes d’Anis étoilé 10 gouttes de Cannelle de Chine 50 gouttes d’huile végétale de Macadamia Massez 6 à 8 gouttes sur le ventre. Et 4 gouttes dans un peu de miel en bouche. 6 fois par jour. HE contre la digestion lente Une synergie pour accélérer le transit : 20 gouttes de Coriandre 15 gouttes de Fenouil 15 gouttes de Menthe poivrée 50 gouttes d’huile végétale de Macadamia Appliquez 12 gouttes sur le ventre et massez 4 fois par jour. Et 4 gouttes en bouche 3 ou 4 fois par jour. HE contre nausées et mal des transports La synergie qui viendra rapidement à bout des nausées, mais aussi du mal des transports, d’une indigestion ou de lourdeurs après un repas copieux. À toujours avoir sous la main. 30 gouttes de Menthe poivrée 10 gouttes de Citron (zeste) 10 gouttes de Gingembre 50 gouttes d’huile végétale de Macadamia 4 gouttes en bouche à renouveler au besoin. Le choix Pranarōm Pranarōm, expert en aromathérapie, propose des huiles essentielles chémotypées 100 % pures et biologiques. Choisir Pranarōm, c’est opter pour des huiles essentielles de qualité supérieure qui garantiront une efficacité et une pureté maximales pour rééquilibrer votre digestion.
Hyperhidrose : comment la soulager naturellement ?
L’hyperhidrose, comment soulager sa transpiration excessive ? L’hyperhidrose, ou transpiration excessive est un problème courant qui touche environ 3 % de la population mondiale. Elle peut être source d’anxiété et affecte la qualité de vie des personnes qui en souffrent. Heureusement, des solutions naturelles existent pour aider à contrôler cette sudation excessive, en complément des traitements médicaux conventionnels. Qu’est-ce que l’hyperhidrose ? La transpiration est un phénomène naturel utilisé par le corps pour abaisser sa température lorsque celle-ci augmente trop. L’hyperhidrose est une affection caractérisée par une transpiration qui dépasse largement les besoins du corps en termes de régulation thermique. Elle peut se manifester de manière localisée, et toucher principalement les aisselles, les paumes des mains, les plantes des pieds, ou encore le visage. Dans des cas plus rares, elle peut être généralisée et affecter l’ensemble du corps. Hyperhidrose localisée L’hyperhidrose localisée est la plus courante. Elle est souvent déclenchée par des facteurs tels que le stress, l’anxiété, ou la chaleur. Elle apparaît généralement dès l’enfance ou l’adolescence et peut s’atténuer avec l’âge. Hyperhidrose généralisée Moins fréquente, Hyperhidrose généralisée est souvent liée à des conditions médicales sous-jacentes comme l’hyperthyroïdie, le diabète, ou certaines infections. Elle nécessite un diagnostic médical pour en identifier la cause précise. Quels sont les symptômes de l’hyperhidrose ? L’hyperhidrose se manifeste par une sudation excessive qui peut survenir sans raison apparente, même en l’absence de chaleur ou d’activité physique. Les principaux symptômes incluent : Transpiration abondante qui mouille les vêtements, souvent accompagnée de mauvaises odeurs. Mains et pieds moites, ce qui rend la manipulation d’objets difficile. Auréoles sous les bras, visibles même avec des vêtements clairs. Peau glissante, particulièrement sur les paumes, provoquant une gêne au quotidien. Ces symptômes peuvent entraîner une anxiété sociale et une altération de la vie professionnelle, due à la crainte de transpirer en public. Comment diagnostiquer l’hyperhidrose ? Le diagnostic de l’hyperhidrose repose sur une combinaison d’observations cliniques et d’examens médicaux. Il s’agit d’évaluer l’intensité de la transpiration et en déterminer la cause sous-jacente : Consultation initiale : le médecin commencera par recueillir un historique médical détaillé, en se concentrant sur la fréquence, la localisation et les déclencheurs de la transpiration excessive. Confirmation du diagnostic : le médecin peut recourir à des tests, tels que le test de l'iode-amidon, qui permet de visualiser la zone affectée par la transpiration excessive. Une fois le diagnostic posé, il est essentiel de déterminer si l’hyperhidrose est primaire ou secondaire afin d’orienter le traitement de manière appropriée. Hyperhidrose primaire Sans cause identifiée, l’hyperhidrose primaire se manifeste souvent au niveau des aisselles, des mains et des pieds. Elle est souvent déclenchée par : Émotions fortes et stress ; Températures élevées ; Aliments épicés ou alcool ; Efforts physiques ; Facteurs génétiques (25 % sont des cas familiaux). Hyperhidrose secondaire L’hyperhidrose primaire est liée à des conditions médicales sous-jacentes, telles que : Maladies endocriniennes (ex. : hyperthyroïdie) ; Infections (ex. : tuberculose) ; Conditions neurologiques (ex. : maladie de Parkinson) ; Troubles anxieux ; Certains médicaments (ex. : antidépresseurs). Les huiles essentielles contre l’hyperhidrose Grâce à leurs propriétés astringentes, antibactériennes, régulatrices et purifiantes, les huiles essentielles peuvent aider à atténuer la transpiration excessive. Huile essentielle de Sauge Sclarée pour réguler la transpiration L’huile essentielle de Sauge Sclarée est l’une des huiles les plus efficaces pour réguler la transpiration excessive. Grâce à ses propriétés régulatrices hormonales et anti-transpirantes (action antisudorifique du sclaréol), elle aide à diminuer la production de sueur. Elle a également une action calmante (grâce au linalol et l’acétate de linalyle) qui permet de réduire le stress et l’anxiété, des facteurs déclenchants de la transpiration. Enfin, son action anti-infectieuse aide à combattre des micro-organismes en cause dans les mauvaises odeurs. Pour une utilisation optimale : Voie cutanée : mélangez 3 ou 4 gouttes d’huile essentielle de Sauge Sclarée dans une huile végétale (jojoba, coco, etc.) et appliquez sur les zones concernées, comme les aisselles ou les pieds, après la douche. Inhalation : déposez 1 à 2 gouttes sur un mouchoir et respirez profondément pour bénéficier de ses effets calmants. Voie orale : pour soulager les bouffées de chaleur, déposez 1 à 2 gouttes sur un support neutre 2 à 3 fois par jour. Contre-indications L’huile essentielle de Sauge Sclarée est : Déconseillée aux femmes enceintes et allaitantes ; Déconseillée aux enfants de moins de 6 ans ; Contre-indiquée en cas de cancers hormono-dépendants (cancer du sein par exemple). Faites toujours un test cutané avant utilisation : 2 gouttes du mélange dans le creux du coude pour vérifier une absence de réaction pendant 24 h. Huile essentielle de Palmarosa contre les mauvaises odeurs Souvent reconnue comme le déodorant naturel, l’huile essentielle de Palmarosa est avant tout une huile antibactérienne puissante à large spectre (géraniol). Cette propriété lui permet de lutter contre les bactéries responsables des mauvaises odeurs en cas de transpiration excessive. Antifongique, elle contribue aussi à lutter contre les champignons des mycoses favorisées par la transpiration. Elle laissera également une odeur florale, similaire à la rose, sur la peau. Pour une utilisation optimale : Mélangez 3 ou 4 gouttes d’huile essentielle de Palmarosa dans une huile végétale et appliquez sur la zone concernée ; Ajoutez quelques gouttes dans un déodorant naturel fait maison ; Vaporiser un hydrolat de Palmarosa sur les pieds. Contre-indications L’huile essentielle de Palmarosa est à éviter chez les femmes enceintes, surtout pendant les trois premiers mois, et chez les enfants de moins de 6 ans. Il est recommandé de réaliser un test cutané. Huile essentielle de Ciste Ladanifère pour resserrer les pores L’huile essentielle de Ciste Ladanifère est réputée pour ses propriétés astringentes. Elle va resserrer les pores sudoripares présents sur la paume des mains, la plante des pieds et le front. Cette action permet de réguler la transpiration excessive. Elle aide également à maintenir la peau en bonne santé en favorisant la cicatrisation des petites irritations cutanées souvent causées par la transpiration. Pour une utilisation optimale : Mélangez 3 ou 4 gouttes d’huile essentielle de Ciste Ladanifère avec une huile végétale comme l’huile de jojoba, puis appliquez ce mélange sur les zones sujettes à la transpiration excessive, comme les mains ou les pieds. Ajoutez quelques gouttes à votre déodorant naturel pour renforcer son efficacité. Contre-indications L’huile essentielle de Ciste Ladanifère doit être utilisée avec précaution. Elle est déconseillée aux femmes enceintes et allaitantes, et aux enfants de moins de 6 ans. Il est recommandé de réaliser un test cutané. Synergie d’huiles essentielles pour combattre la transpiration excessive Mélangez les huiles suivantes : 60 gouttes d’huile essentielle de Sauge Sclarée ; 60 gouttes d’huile essentielle de Palmarosa ; 30 gouttes d’huile essentielle de Ciste. Appliquez 1 goutte du mélange sur chaque aisselle, pied ou main 2 fois par jour si nécessaire. À appliquer 5 jours sur 7 pour éviter de l’utiliser tous les jours. Ce mélange est déconseillé aux femmes enceintes et allaitantes et aux enfants de moins de 6 ans. Déodorant baume DIY Ce déodorant naturel à la texture onctueuse, doux pour la peau et facile à appliquer, vous protégera des mauvaises odeurs. Pour composer la synergie : 15 gouttes d’HE de Palmarosa ; Aloe vera : quantité suffisante pour remplir un flacon de 60 ml. Appliquez-le sous les aisselles en massant pour faire pénétrer. Une pression de pompe suffit pour les 2 aisselles. Les huiles végétales contre la transpiration excessive En complément des huiles essentielles, certaines huiles végétales peuvent jouer un rôle dans la gestion de la transpiration excessive, en hydratant et en protégeant la peau. Huile végétale de noix de coco L’huile végétale de noix de coco est reconnue pour ses propriétés hydratantes et antibactériennes. Elle aide à maintenir la peau douce tout en neutralisant les odeurs. Pour une utilisation optimale : Appliquez une petite quantité sous les aisselles ou sur les pieds après la douche ; Elle peut également servir de base pour diluer des huiles essentielles. Contre-indications L’huile végétale de noix de coco ne connaît aucune contre-indication pour un usage externe. Évitez l’application sur les zones très grasses de la peau. Huile végétale de jojoba L’huile végétale de jojoba est une excellente option pour réguler la production de sébum. Elle est légère et non comédogène, idéale pour les peaux sujettes à la transpiration excessive. Pour une utilisation optimale : Utilisez-la comme base pour diluer des huiles essentielles ; Appliquez-la directement sur la peau pour une hydratation en profondeur. Contre-indications Aucun effet secondaire connu pour un usage externe. Elle est équilibrante et non comédogène, elle convient donc à tout type de peau. Elle fait d'ailleurs partie des huiles végétales indispensables en été. L’hyperhidrose peut être une condition difficile à vivre, mais elle n’est pas sans solution. En intégrant des huiles essentielles et végétales dans votre routine quotidienne, vous pouvez atténuer les symptômes de manière naturelle. N’oubliez pas de consulter un professionnel de santé pour un diagnostic précis et un suivi adapté, surtout si la transpiration excessive persiste ou s’aggrave.